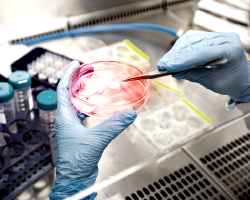

AVAILABLE 24 HOURS A DAY, 7 DAYS A WEEK
THE NARCONON PROGRAM
Find out more about what makes Narconon different from any other rehab program in the world
Narconon Drug Rehabilitation Drug-free Withdrawal New Life Detoxification LifeSkills Testimonials Drug Rehabilitation
OUR HISTORY.
OUR TECHNOLOGY
Find out about the key to Narconon’s history of success
About Narconon Global Mission 50 Years: Saving Lives World-Class Facilities Narconon International Science Advisory Board Recognition & Appreciation Studies & Reports Narconon Editorial Team L. Ron HubbardADDITIONAL INFORMATION
For counselors, drug rehabilitation professionals and concerned family members
More Information Program Information Portfolio Request More Info Contact Narconon Addiction Treatment Support & Resources Drug & Alcohol InformationNARCONON AROUND THE WORLD
Narconon is a global success story
Narconon.org United States Europe United Kingdom Latin America Nepal Africa Narconon LocationsLanguage: English (US)
© 2026
Narconon International.
All Rights Reserved. • Online Privacy Notice •
Cookie Policy •
Terms of Use • Notice of Privacy Practices
• Disclaimer: Individual results are not guaranteed and may vary.
Narconon and the Narconon logo are trademarks and service marks owned by the Association for Better Living and Education International and are used with its permission.